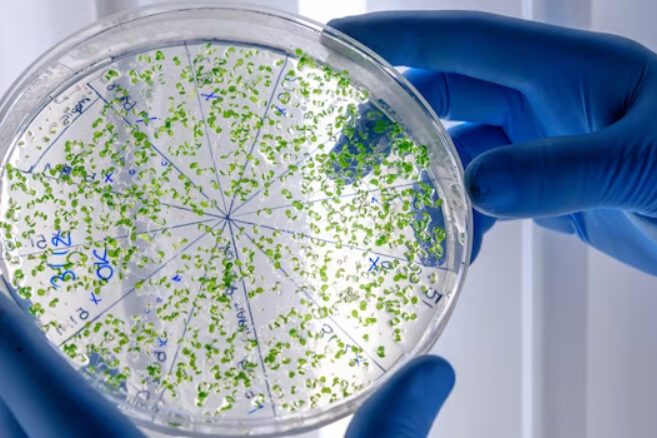
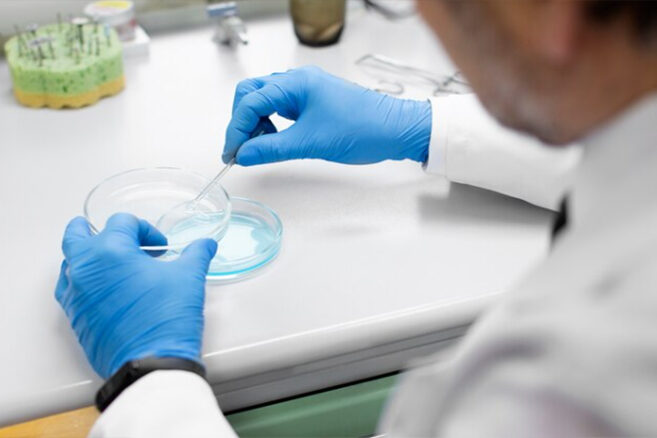

Мікрофлора кишківника, також відома як мікробіом кишківника, є сукупністю мікроорганізмів, в основному бактерій, які населяють кишківник людини і виконують ряд важливих функцій для здоров’я організму.
Мікрофлора кишківника складається з понад 1000 видів бактерій, а також грибів, вірусів та інших мікроорганізмів. Ці мікроорганізми перебувають у симбіотичних відносинах з людиною, взаємодіючи з його імунною системою та беручи участь у травленні та інших фізіологічних процесах.
Функції мікрофлори кишківника
-
- Травлення. Мікроорганізми в кишківнику допомагають розщеплювати харчові речовини, такі як клітковина та деякі вуглеводи, які людський організм не здатний перетравлювати самостійно. Вони також допомагають синтезувати певні вітаміни, такі як вітамін K та вітаміни групи B.
- Зміцнення імунної системи.Мікроорганізми мікрофлори кишківника взаємодіють з імунною системою, допомагаючи їй правильно реагувати на патогени та розвивати захисні реакції. Вони також можуть знижувати ризик розвитку алергічних та запальних захворювань.
- Захист від патогенних мікроорганізмів. Мікроорганізми мікрофлори кишківника конкурують з патогенними мікроорганізмами за поживні речовини та місце проживання, тим самим допомагаючи запобігати їх розмноженню та захищаючи організм від інфекцій.
- Регуляція обміну речовин. Мікрофлора кишківника впливає на обмін речовин в організмі, у тому числі на рівень глюкози, ліпідів та інших метаболітів, що впливає на здоров’я серця, метаболічний синдром.
Які симптоми порушення мікрофлори кишківника?
Порушення мікрофлори кишківника, також відоме як дисбактеріоз, проявляється різними симптомами, які змінюються в залежності від конкретного стану та ступеня порушення. Деякі із загальних симптомів порушення мікрофлори кишківника включають:
- Шлунково-кишкові симптоми. Діарея, запори, здуття живота, гази, надмірне утворення повітря в кишківнику, захворювання кишківника, такі як синдром подразненого кишківника.
- Зміни апетиту та ваги. Втрата апетиту, зниження чи підвищення маси тіла.
- Послаблення імунної системи. Підвищена сприйнятливість до інфекцій, підвищена чутливість до алергічних реакцій, погіршення здоров’я шкіри.
- Психологічні симптоми. Зміни настрою, дратівливість, погіршення психічного стану, такі як депресія та тривожність.
- Погіршення загального стану здоров’я. Втома, зниження енергії, зниження працездатності.
- Погіршення стану шкіри. Висипання на шкірі, почервоніння, свербіж, висипання.
- Інші симптоми. Головний біль, зубні проблеми, смердючий запах з рота.
- Порушення випорожнень. Часті запори або діарея, зміна консистенції випорожнень, його забарвлення, запаху або текстури.
- Здуття живота. Відчуття переповненості, тяжкості чи розширення живота.
- Біль у животі. Болі в животі, які можуть бути спазмами або короткочасними коліками.
- Газоутворення. Надмірне виділення газів через рот або анальний отвір.
- Незадовільне травлення. Почуття, що їжа не перетравлюється належним чином.
- Слабкість і втома. Відчуття втоми, розбитості та нестачі енергії.
- Порушення імунної системи. Часті застудні захворювання, алергії, чутливість до продуктів харчування та навколишнього середовища.
Однак ці симптоми не є специфічними і пов’язані з іншими захворюваннями. Тому при підозрі на дисбактеріоз необхідно звернутися до лікаря для діагностики та лікування.
Відновлення мікрофлори кишківника
Для відновлення порушеної мікрофлори кишківника вживають таких заходів:
- Зміна дієти. Харчування відіграє у формуванні мікробіома кишківника. Споживання більшої кількості овочів, фруктів, зелені, цільнозернових продуктів і багатих на пребіотики продуктів (наприклад, цибуля, часник, артишок, банани, цикорій) стимулює зростання корисних бактерій у кишківнику.
- Пробіотики. Це живі бактерії, які корисні для мікробіома кишківника. Вони вживаються у вигляді добавок або через певні продукти, такі як йогурт чи кефір.
- Прийом пребіотиків. Пребіотики – це харчові волокна, які не перетравлюються, але які живлять корисні бактерії в кишківнику, допомагаючи їм рости та розвиватися. Пребіотики отримують з певних продуктів, таких як цибуля, часник, цикорій, артишок та банани.
- Обмеження антибіотиків. Прийом антибіотиків негативно впливає на мікробіом кишківника, вбиваючи корисні бактерії. Тому, якщо можливо, слід обмежити використання антибіотиків.
- Управління стресом. Стрес впливає на мікробіом кишківника. Тому слід використовувати методи керування стресом, такі як медитація, йога або релаксація.
- Фізична активність. Регулярна фізична активність допоможе поліпшити мікробіом кишківника.
- Лікування основного захворювання. Якщо порушення мікрофлори кишківника викликане захворюванням, необхідно звернутися до лікаря для призначення лікування. В цілому, відновлення здорової мікрофлори кишківника вимагає змін у дієті та стилі життя, а також використання пробіотиків та/або пребіотиків, і в деяких випадках, лікарських засобів.
- Програма очищення організму
- Проведення протипаразитарної програми